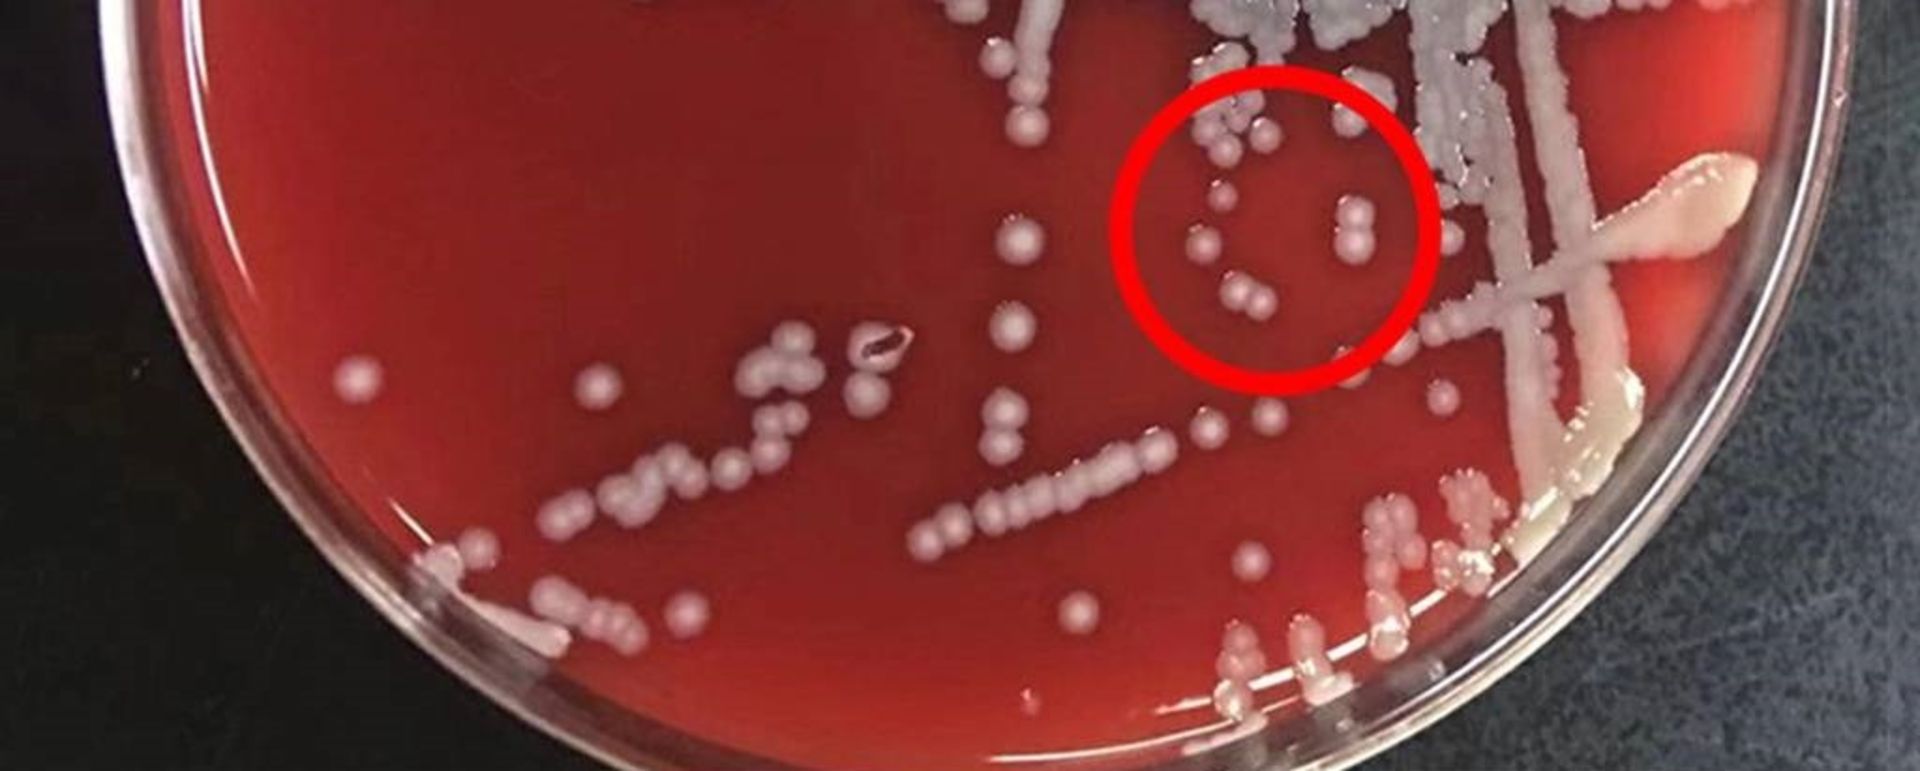
باکتری کلبسیلا آئروژنز

شناسایی آنزیمی که میتواند در برخی افراد موجب افسردگی شود

مدتی است میدانیم بین هورمونها، رودهها و سلامت روان ما تعامل پیچیدهای وجود دارد، اما کشف ارتباطات دقیق درون بدن چالشبرانگیز بوده است. پژوهش جدیدی آنزیمی را پیدا کرده که هر سه مورد مذکور را به هم مرتبط میکند و وجود آن ممکن است علت افسردگی در برخی از زنان در طول سالهای باروری باشد.
دی لی، پژوهشگر پزشکی دانشگاه ووهان و همکارانش سرم خون ۹۱ زن ۱۸ تا ۴۵ ساله مبتلا به افسردگی و ۹۸ زن غیرمبتلا را با هم مقایسه کردند. بهطور باورنکردنی، سطح سرمی استرادیول (شکل اولیه استروژنی که بدن در طول سالهای باروری از آن استفاده میکند) در افرادی که دچار افسردگی بودند، تقریبا نصف بود.
ساینس آلرت مینویسد، این ایده که در افراد دارای هورمونهای زنانه دارای قدرت باروری، استرادیول با افسردگی ارتباط دارد، بیش از ۱۰۰ سال قدمت دارد. کاهش طبیعی در استرادیول در طول یائسگی و پس از بارداری با تغییرات خلقی منفی مرتبط است.
مشکلات دیگر ازجمله سندرم تخمدان پلی کیستیک (که در آن تخمدانها سطوح بالاتر از حد طبیعی هورمونهای جنسی به نام آندروژنها را تولید میکنند و موجب عدم تعادل هورمونهای تولیدمثلی میشوند) و هیپرپلازی مادرزادی آدرنال (گروهی از اختلالات ژنتیکی که در آن بدن فاقد یکی از آنزیمهای موردنیاز برای ساخت هورمونهای خاص است) نیز میتوانند موجب کاهش سطوح استرادیول و افسردگی شوند.
ارتباط افسردگی با استرادیول احتمالا توضیح میدهد که چرا شیوع افسردگی در زنان دو برابر مردان است.
استرادیول در تخمدانها تولید میشود و پس از انجام وظایف خود در بدن (ازجمله تنظیم چرخه قاعدگی) در کبد متابولیزه میشود و سپس به روده منتقل میشود. در روده، این هورمون تا حدی دوباره جذب گردش خون میشود تا به حفظ سطح استروژن در گردش خون کمک کند.
با این دانش، پژوهشگران فعالیتهای استرادیول را در روده بررسی کردند. در عرض دو ساعت از اضافه کردن استرادیول به نمونههای میکروبیوم مدفوع زنان مبتلا به افسردگی، ۷۸ درصد هورمون تخریب شد. در همین حین، لوله حاوی نمونههای میکروبیوم زنان غیرمبتلا فقط ۲۰ درصد کاهش در هورمون را نشان داد.
دانشمندان همچنین میکروبیوتای روده ۵ زن مبتلا به افسردگی را به موشها پیوند زدند. سطح استرادیول سرم خون این موشها درمقایسهبا موشهای گروه کنترل، ۲۵ درصد کاهش داشت. با این نتایج، واضح بهنظر میرسید که یکی از میکروبهای روده مسئول افزایش تخریب این هورمون در دستگاه گوارش است.
لی و گروهش بهمنظور جداسازی میکروب مسئول این امر، نمونههای میکروبیوم زنان مبتلا به افسردگی را در ظرف آگار قرار دادند و استرادیول را بهعنوان تنها منبع غذایی در اختیار آنها قرار دادند. دو ساعت بعد، بیش از ۶۰ درصد از استرادیول به استرون تجزیه شده بود. حبابهای سفید دارای لبههای صاف و تار ظاهر شدند و پژوهشگران با استفاده از طیفسنجی جرمی میکروب را شناسایی کردند: سویهای از باکتری که آن را کلبسیلا آئروژنز TS2020 نامیدند. پژوهشگران در مقاله خود توضیح میدهند: «این نتایج نشان میدهد کلبسیلا آئروژنز TS2020 میتواند سطح استرادیول را در موشها کاهش دهد و موجب رفتارهای افسرده شود. علاوهبراین، استفاده از سفوتاکسیم میتواند رفتارهای افسرده را در موشها کاهش دهد.»
تجزیهوتحلیل ژنتیکی نشان داد کلبسیلا آئروژنز به کمک آنزیم 3-بتا-هیدروکسی استروئید دهیدروژناز (3β-HSD) استرادیول را به استرون تبدیل میکند. قرار دادن این ژن در باکتری ایکولای و سپس آلودهکردن موشها به این باکتری موجب کاهش استرادیول و بروز علائم افسردگی شد. دادن استرون به موشهای گروه کنترل رفتار افسردگی را افزایش نداد و استرون اضافی بهعنوان علت افسردگی رد شد. لی و همکارانش نقش احتمالی مولکولهای دیگر را نیز رد کردند.
موشهای دارای ایکولای تولیدکننده آنزیم 3β-HSD همچنین دارای سطوح استرادیول پایینتری در مغز و ازجمله در هیپوکامپ بودند. هیپوکامپ منطقهای از مغز است که نقش مهمی در افسردگی دارد. درمجموع، این یافتهها نشان میدهد آنزیم تولیدشده توسط میکروب علت ایجاد مشکلات مغزی است.

در مطالعه قبلی، پژوهشگران افزایش سطح آنزیم 3β-HSD را در بیماران مرد افسرده شناسایی کرده بودند. این آنزیم همچنین میتواند تستوسترون را تخریب کند. پژوهشگران توضیح میدهند: «با درنظر گرفتن این دو مطالعه، حدس میزنیم که آنزیم 3β-HSD در ایجاد افسردگی نقش دارد و این رابطه مستقل از جنس است. معتقدیم که K. aerogenes در مدفوع تنها باکتری روده نیست که میتواند 3β-HSD را تولید کند. دادههای توالییابی متاژنومیک ما نشان داد باکتریهای ﺑﺎﮐﺘﺮوﺋﯿﺪس ﺗﺘﯿﺎﺗﻮﻣﯿﮑﺮون و کلستریدیا نیز دارای آنزیم مذکور هستند. ممکن است باکتریهای دیگری نیز در روده وجود داشته باشند که مقدار تولید آنزیم 3β-HSD آنها کمتر از حدی باشد که در توالییابی متاژنومیک تشخیص داده شود. این موضوع که کدام باکتریها میتوانند آنزیم 3β-HSD را تولید کنند، به مطالعه بیشتر نیاز دارد.»
گروههایی از پژوهشگران روی درمان جایگزینی استروژن بهعنوان درمان احتمال برای افسردگی در زنان تمرکز کردهاند، اما بهگفتهی لی و گروهش، اگر مسیری که در مطالعه آنها شناسایی شده است، صحیح باشد، باکتریهای تولیدکننده 3β-HSD میتوانند موجب عود شود. آنها خاطرنشان میکنند: «باکتریهای تجزیهکننده استرادیول در روده و خصوصاً آنزیمهایی که توسط آنها بیان میشود، ممکن است اهداف بهتری برای مداخله باشند.»
حدود ۲۸۰ میلیون نفر در سراسر جهان از افسردگی رنج میبرند. افرادی که برای درمان افسردگی خود به کمکهای خارجی متکی هستند، بیصبرانه منتظر گزینههای درمانی بهتری هستند که از درک ارتباطات بین مغز، روده و هورمونها حاصل میشود.
این پژوهش در مجلهی Cell Metabolism منتشر شد.


